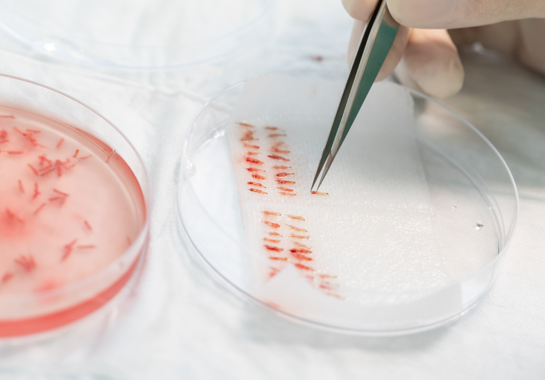

Greffe de cheveux : évolution mois par mois


La greffe de cheveux s’est imposée comme une solution efficace pour contrer la perte capillaire. Cette intervention chirurgicale consiste à déplacer des follicules pileux d’une zone donneuse, généralement l’arrière du crâne, vers les zones touchées par la calvitie. Les techniques ont considérablement progressé au fil du temps, offrant des résultats de plus en plus naturels et durables.
Actuellement, la technique de pointe est la DHI (Direct Hair Implantation). Contrairement à la FUE (Follicular Unit Extraction) qui nécessite deux étapes distinctes – extraction puis implantation – la DHI permet une implantation directe des follicules grâce à un stylo spécialisé. Cette méthode offre une précision supérieure, minimise le temps hors corps des greffons et permet d’atteindre une densité potentiellement plus élevée.

Comprendre l’évolution post-greffe aide à gérer les attentes et à optimiser les résultats. Voici un aperçu détaillé de ce à quoi vous pouvez vous attendre mois après mois, jusqu’à un an après la procédure, avec un regard sur les résultats à long terme.
Préparation à la greffe
Une consultation approfondie précède l’intervention. Le chirurgien évalue l’étendue de votre perte de cheveux, la qualité de votre zone donneuse et discute de vos attentes. Des examens sanguins confirment votre aptitude à subir l’intervention.
Il vous sera demandé d’arrêter certains médicaments, comme l’aspirine, deux semaines avant l’opération. L’alcool et le tabac sont à éviter la semaine précédant la greffe. La veille, vous utiliserez un shampooing spécial pour préparer votre cuir chevelu.

Jour de la procédure
Le jour J, la zone donneuse est rasée. Une anesthésie locale assure votre confort. Avec la technique DHI, les follicules sont extraits individuellement à l’aide d’un micro-poinçon, puis immédiatement chargés dans le stylo implanteur. Cet outil permet de créer le site receveur et d’implanter le greffon en un seul geste, réduisant ainsi le traumatisme et améliorant la précision du placement.
L’intervention dure généralement entre 6 et 8 heures, selon le nombre de greffons. À la fin de la procédure, votre cuir chevelu présentera de petits points rouges dans la zone receveuse, avec un aspect légèrement « hérissé » tout à fait normal.

10 jours après la greffe
Dans les jours qui suivent, de petites croûtes se forment autour des greffons, signe que le processus de cicatrisation est en cours. Vous pourrez ressentir des démangeaisons, mais il est essentiel de ne pas gratter. Suivez scrupuleusement les instructions de lavage fournies par votre chirurgien et utilisez la solution saline ou le spray fourni pour hydrater votre cuir chevelu.
Vers le 7e-10e jour, les croûtes commencent à tomber naturellement. Ne forcez pas ce processus. C’est également à ce moment que vous pourrez observer les premiers signes de repousse des cheveux natifs dans la zone receveuse.

1 mois après la greffe
Le premier mois marque le début de la phase de repos (télogène) pour les follicules transplantés. Vous constaterez une chute des cheveux transplantés, un phénomène appelé « shock loss ». Rassurez-vous, c’est parfaitement normal et attendu. Les racines restent en place et se préparent pour la nouvelle phase de croissance.
À ce stade, les zones greffées peuvent sembler clairsemées. Les rougeurs et l’enflure initiales devraient avoir disparu. Vous pouvez reprendre vos activités normales, y compris l’exercice léger. Continuez à laver doucement votre cuir chevelu et évitez l’exposition prolongée au soleil.

2 mois après la greffe
Deux mois après l’intervention, la plupart des follicules sortent de leur phase de repos. Vous pourriez observer l’apparition de cheveux très fins et clairs, bien que la repousse ne soit pas uniforme. Il est possible que de petits boutons (folliculite) apparaissent, mais ils sont généralement bénins et disparaissent d’eux-mêmes.
Continuez à masser doucement votre cuir chevelu pour stimuler la circulation. Si votre chirurgien vous a prescrit des traitements complémentaires comme le minoxidil ou le finastéride, c’est généralement à ce stade que vous commencerez à les utiliser.

3 mois après la greffe
Le troisième mois marque souvent le début d’une repousse visible pour de nombreux patients. Les nouveaux cheveux sont généralement fins et clairs au début. Leur texture peut être différente de vos cheveux d’origine, mais cela s’améliorera avec le temps.
La repousse n’est pas uniforme, certaines zones peuvent sembler plus denses que d’autres. Vous pouvez commencer à coiffer doucement ces nouveaux cheveux, mais évitez les traitements agressifs comme la décoloration ou la permanente.
Une consultation de contrôle est généralement prévue à ce stade pour évaluer la progression et ajuster les soins si nécessaire.

4 mois après la greffe
À quatre mois, vous devriez constater une augmentation notable de la densité capillaire. Plus de follicules entrent en phase de croissance, et les cheveux commencent à s’épaissir et à foncer. Leur longueur est généralement suffisante pour commencer à couvrir le cuir chevelu, et leur texture se rapproche progressivement de celle de vos cheveux d’origine.
La ligne frontale commence à se définir plus clairement, bien que certaines zones puissent encore sembler clairsemées. Vous pouvez maintenant utiliser des produits coiffants légers et envisager une coupe de cheveux, mais avec précaution.

6 mois après la greffe
Six mois après l’intervention, les résultats deviennent vraiment visibles. Les cheveux sont plus épais, plus foncés, et la densité est significativement améliorée. Environ 60 à 70% des greffons ont généralement poussé à ce stade. La direction et l’angle de pousse se stabilisent, donnant une apparence plus naturelle.
C’est généralement à ce moment que vous pouvez avoir votre premier rendez-vous chez le coiffeur. Les nouveaux cheveux se mêlent mieux aux cheveux existants, et la ligne frontale commence à paraître naturelle. Vous pouvez utiliser normalement des shampooings et des produits coiffants.
Une consultation de suivi est recommandée pour évaluer la progression et discuter de la nécessité éventuelle d’une retouche.

9 mois après la greffe
Neuf mois après la greffe, l’amélioration de la densité et de l’épaisseur des cheveux est continue. À ce stade, 80 à 90% des greffons ont généralement poussé. Les cheveux sont plus épais et plus résistants, leur texture et leur couleur très proches de vos cheveux d’origine.
Vous pouvez maintenant adopter des styles de coiffure plus variés. La majorité des patients peuvent apprécier l’essentiel du résultat, avec une ligne frontale et une densité globale bien établies. L’impact positif sur la confiance en soi est souvent notable à ce stade.

1 an après la greffe
À un an, le résultat final est généralement atteint. La croissance est complète pour 90 à 100% des greffons, avec une densité, une texture et une direction des cheveux optimales. C’est le moment d’évaluer le résultat définitif et de le comparer avec les objectifs initiaux.
Les cheveux greffés se comportent désormais comme vos cheveux naturels. Vous pouvez les couper, les colorer et les coiffer normalement. Il est important de continuer les traitements contre la chute si votre chirurgien les a prescrits, car ils aident à maintenir les résultats à long terme.
Pour certains patients, une deuxième séance peut être envisagée à ce stade pour augmenter davantage la densité, en fonction de la disponibilité de la zone donneuse restante.

10 ans après la greffe
À long terme, les résultats d’une greffe de cheveux bien réalisée sont durables. Les cheveux greffés sont généralement résistants à la chute et maintiennent leur densité dans les zones traitées. Cependant, il est normal qu’ils évoluent naturellement, pouvant grisonner ou légèrement s’affiner avec l’âge.
Facteurs influençant les résultats
Plusieurs facteurs influencent le succès d’une greffe de cheveux. La qualité et la quantité des follicules donneurs sont déterminantes. La technique utilisée, en particulier la DHI, offre des avantages significatifs en termes de survie des greffons et de densité obtenue.
L’expertise du chirurgien est un facteur clé. Un praticien expérimenté en DHI saura maximiser les résultats. Le suivi rigoureux des instructions post-opératoires par le patient joue également un rôle majeur dans la qualité des résultats.
Des facteurs individuels comme l’âge, le type de perte de cheveux, la santé générale et les habitudes de vie influencent aussi l’issue de la greffe. L’utilisation de traitements complémentaires comme le minoxidil ou le finastéride peut optimiser et maintenir les résultats à long terme.

Conclusion
La greffe de cheveux, en particulier avec la technique DHI, offre une solution durable à la perte de cheveux. Le processus de repousse est graduel, nécessitant patience et soins appropriés. Les résultats s’améliorent progressivement au fil des mois, avec un résultat final généralement visible après un an.
Il est essentiel de choisir un chirurgien expérimenté et de suivre scrupuleusement les instructions post-opératoires. Avec les bons soins et un suivi adéquat, les résultats peuvent être maintenus sur le long terme, offrant une amélioration significative de l’apparence et de la confiance en soi.
La greffe de cheveux est un investissement à long terme dans votre apparence. Bien que le processus puisse sembler long, les résultats finaux en valent souvent la peine, offrant une solution naturelle et durable à la perte de cheveux.
Sources :
- Gentile, P., & Garcovich, S. (2020). Advances in Regenerative Stem Cell Therapy in Androgenic Alopecia and Hair Loss: Wnt pathway, Growth-Factor, and Mesenchymal Stem Cell Signaling Impact Analysis on Cell Growth and Hair Follicle Development. Cells, 8(5), 466.
- Parsley, W. M., & Perez-Meza, D. (2010). Review of factors affecting the growth and survival of follicular grafts. Journal of Cutaneous and Aesthetic Surgery, 3(2), 69-75.
- Liu, D., Xu, Q., Meng, X., Liu, X., & Liu, J. (2024). Status of research on the development and regeneration of hair follicles. International Journal of Medical Sciences, 21(1), 80-97.
- Rose, P. T. (2015). Hair restoration surgery: challenges and solutions. Clinical, Cosmetic and Investigational Dermatology, 8, 361–370.
- Dua, A., & Dua, K. (2010). Follicular unit extraction hair transplant. Journal of Cutaneous and Aesthetic Surgery, 3(2), 76–81.
Avant-Après
Découvrez les résultats de nos patients





































On discute de votre projet
Nos patients
parlent de nous

